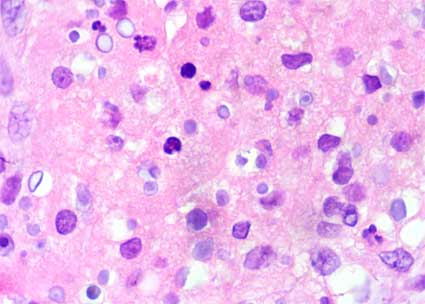
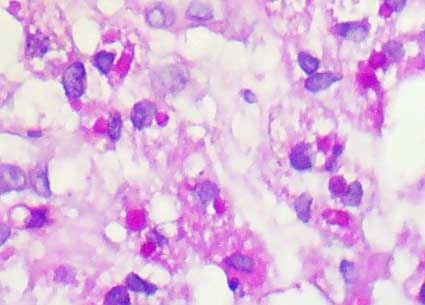

CASO
35 (Enero 2009)
Datos clínicos
Mujer de 22 años de edad. Fue
hospitalizada por tumefacción y dolor lumbar progresivos, además
presentaba fiebre y malestar general, varios meses de evolución.
Ella tenía una historia de 12 años de síntomas intermitentes
sugerentes de infección de vías urinarias a repetición.
No se habían hecho exámenes para el estudio de infecciones
urinarias recurrentes.
Al examen físico se identifica
un trayecto fistuloso a piel en la región lumbar. Pruebas de laboratorio
muestran función renal normal. El uroanálisis mostró
numerosos leucocitos, sin otros hallazgos específicos. Una tomografía
revela que el riñón derecho está desplazado y comprimido
por una lesión quística homogénea, bien definida,
que está en contacto con la pelvis renal. Adyacente hay una masa
retroperitoneal mal definida que está en contacto con el psoas
y que conecta con el trayecto fistuloso (Figura 1). El riñón
izquierdo aparece normal.
Se hace resección de la lesión
renal y se toma biopsia de la masa retroperitoneal.
Observe las imágenes.

Figura 1.
TC, el riñón (flecha roja) está desplazado por una
lesión quística cercana al hilio (flechas azules). Se evidencia,
además, una masa retroperitoneal que llega hasta región
lumbar donde hay fístula cutánea (flechas verdes).

Figura 2.
Periferia de la lesión quística. H&E, X100.

Figura 3.
Periferia de la lesión quística. H&E, X400.

Figura 4.
Masa retroperitoneal. H&E, X400.
Figura 5.
Masa retroperitoneal. H&E, X400.

Figura 6.
Masa retroperitoneal. H&E, X400.

Figura 7.
Masa retroperitoneal. H&E, X400.

Figura 8.
Masa retroperitoneal. H&E, X1,000.
Figura 9.
Masa retroperitoneal. PAS, X400.
¿Cuál es su diagnóstico?
Ver
diagnóstico y discusión
[Arriba]
|